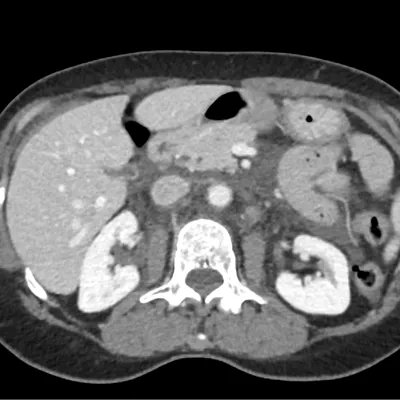
AuntMinnie.com tweet media

Step 2 ✅
1st Sub-I ✅
I start my 2nd Sub-I on Monday.
I have felt incredibly grateful to have had the opportunity to learn from amazing faculty, residents, and attendings. Blessed to be on this journey. #Match2024 #FutureRadRes
Orlando, FL 🇺🇸 English